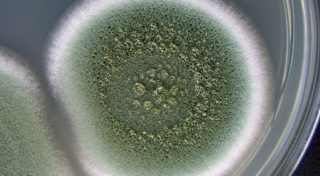

Un humidificateur d'air est un appareil technique conçu pour maintenir un climat intérieur favorable. Au fil du temps, l'humidificateur a besoin d'être réparé ou entretenu. Les appareils de ce type se caractérisent par certains dysfonctionnements. Certains problèmes peuvent être éliminés à la main, d'autres nécessitent de contacter un centre de service.
- But et principe de fonctionnement de l'humidificateur
- Variétés d'appareils
- Entretien humidificateur d'air
- Soins quotidiens
- Service complet
- Désinfection
- Changer les filtres
- Service saisonnier
- Diagnostic des pannes et solutions
- Émetteur
- Générateur
- Élément piézoélectrique
- Ventilateur
- Carte d'alimentation
- Moments de travail
- Puanteur
- Pas de vapeur
- Pas d'air entrant
- Ne fonctionne pas du tout
But et principe de fonctionnement de l'humidificateur

L'humidité, normale pour l'homme, est de 40 à 60%. La façon la plus simple de l'entretenir est d'utiliser une crème hydratante. La nécessité d'utiliser l'appareil est déterminée par l'effet négatif d'un air trop sec sur les meubles en bois de la maison, les plantes d'intérieur et les organes respiratoires. Une faible humidité augmente le risque d'infections.
L'appareil ne sature pas seulement l'air en humidité. Certains appareils peuvent fonctionner comme purificateurs et ioniseurs, ce qui est bénéfique pour la santé des personnes allergiques et asthmatiques.
Il existe trois types d'humidificateurs. Ils diffèrent par leur conception technique et leur principe de fonctionnement :
- vapeur - l'eau dans l'appareil se réchauffe et la vapeur résultante est pulvérisée;
- traditionnel - il n'y a pas de chauffage, l'air passe à travers un filtre humide et, de ce fait, il est nettoyé et saturé d'humidité, après quoi il est pulvérisé dans la pièce;
- ultrasonique - la conception prévoit une membrane qui brise les particules d'eau en plus petites en raison des vibrations qu'elle crée, ce qui entraîne la formation d'un brouillard froid.
Quel que soit le principe de fonctionnement, tous les appareils remplissent une fonction - ils augmentent l'humidité de l'air. Cependant, leur efficacité dépend en grande partie non seulement de la puissance, mais aussi du type d'appareil.
Variétés d'appareils

Les couleurs, les formes et les conceptions des humidificateurs peuvent varier. Les principaux éléments du modèle vapeur sont :
- boîtier extérieur ;
- réservoir d'eau;
- générateur de vapeur;
- élément chauffant;
- refroidisseur d'air;
- unité de contrôle électronique.
Une caractéristique distinctive des humidificateurs à vapeur est la présence d'un élément piézoélectrique qui chauffe l'eau, la transformant en vapeur. Pour cette raison, ils ont plus de puissance, par conséquent, ils consomment plus d'électricité.
La conception du modèle échographique comprend les éléments suivants :
- carte d'alimentation;
- un émetteur fonctionnant dans le domaine ultrasonore ;
- amplificateur;
- ventilateur;
- l'unité électronique.
Dans les humidificateurs traditionnels, l'air est aspiré par un ventilateur, conduit à travers un filtre et soufflé dans la pièce déjà saturée d'humidité.
Entretien humidificateur d'air

L'utilisation continue de l'appareil entraîne une contamination. Cela provoque des dysfonctionnements et raccourcit la durée de vie. En plus de l'entretien quotidien rapide de l'humidificateur, un nettoyage et un remplacement complets des pièces sont essentiels.
Soins quotidiens
L'entretien quotidien consiste à laver l'appareil à l'eau chaude et au savon, dont le but est d'éliminer le mucus et le tartre. Pour un nettoyage plus approfondi, utilisez une brosse.Avant de nettoyer, assurez-vous de débrancher l'appareil et de vider l'eau. Étant donné que l'humidificateur est construit avec des composants électroniques, il doit être lavé très soigneusement afin que l'eau ne coule pas à l'intérieur. Après la procédure, il doit être essuyé avec un chiffon sec et rempli d'eau douce.
Service complet

Un nettoyage en profondeur est effectué tous les trois jours. Après avoir mis l'appareil hors tension et vidé l'eau, essuyez le récipient à l'intérieur avec du vinaigre dilué avec de l'eau. Le réservoir est ensuite soigneusement rincé et séché.
Désinfection
La désinfection est effectuée avec de l'eau de Javel ou du peroxyde d'hydrogène. Sauf indication contraire dans la notice, 100 g de produit sont dilués dans 4 litres d'eau et versés dans le réservoir. Après cela, l'appareil doit être connecté au réseau et attendre la génération de vapeur ou de brouillard, après quoi l'humidificateur est immédiatement éteint. Ensuite, le liquide doit être drainé et le récipient doit être rincé. Remplissez à nouveau d'eau froide et laissez l'appareil fonctionner jusqu'à ce que l'odeur d'eau de Javel disparaisse.
La procédure de désinfection doit être effectuée à l'extérieur ou avec les fenêtres ouvertes.
Changer les filtres
Le filtre de l'humidificateur doit être changé périodiquement. Une fois qu'il devient gris, il est temps de le remplacer. L'utilisation d'un filtre sale est nocive pour la santé, car de minuscules particules de saleté pénètrent dans l'air, qui se déposent ensuite dans les poumons.
Service saisonnier
Avant de ranger l'humidificateur, vous devez le désinfecter, le sécher, puis seulement l'emballer et le mettre sur l'étagère. Choisissez un endroit frais à l'abri de la lumière directe du soleil. Désinfectez à nouveau avant utilisation.
Diagnostic des pannes et solutions

Le diagnostic des dysfonctionnements s'effectue principalement en examinant l'intérieur de l'humidificateur. Après avoir retiré le couvercle arrière, ils vérifient soigneusement toutes les pièces, fils, contacts. Il ne doit pas y avoir de fils déconnectés, d'éléments noircis, gonflés ou fondus.
Émetteur
La défaillance de la membrane est mise en évidence par la présence de fissures ou de fils soudés. Si la membrane semble intacte, elle est essuyée avec une solution de vinaigre de table, mais avant cela, il faut évaluer le degré d'usure, il vaut peut-être mieux ne pas la réparer, mais la remplacer. Pour ce faire, dessoudez les fils de la carte et retirez le support.
Générateur
Pour vérifier le générateur, retirez le couvercle arrière de l'humidificateur, connectez l'appareil au secteur pendant quelques minutes, puis débranchez l'alimentation. Dans ce cas, le radiateur du transistor doit se réchauffer. S'il fait froid, le générateur est défectueux. En présence de tension, alors le transistor de puissance et le générateur d'impulsions de commande sont sonnés. Si vous n'avez pas assez d'expérience et de connaissances pour cela, vous devez contacter le centre de service.
Élément piézoélectrique
L'élément piézoélectrique est responsable du chauffage de l'eau, de sorte que le bon fonctionnement de cette pièce peut être facilement vérifié en faisant bouillir de l'eau quelque temps après avoir allumé l'appareil. Si l'eau ne bout pas, cela indique un dysfonctionnement. Tout d'abord, vous devez vérifier le générateur. Si c'est l'élément piézoélectrique qui tombe en panne, il est changé.
Ventilateur
Le ventilateur doit être nettoyé. La poussière et la graisse ou les débris qui se sont accumulés sur la base peuvent interférer avec sa rotation. Si la procédure n'aide pas, cela signifie que le moteur électrique a grillé et doit être remplacé.
Carte d'alimentation

Vous devez d'abord inspecter le tableau. Les contacts peuvent s'être oxydés et doivent être ressoudés. La présence de taches et de taches sur la planche indique une panne. Un multimètre vous aidera sûrement à le vérifier. Les condensateurs ne doivent pas être gonflés, les résistances doivent être noires. L'unité électronique ne peut pas être réparée sans connaissances particulières, il est donc plus facile de la changer.
Si le filtre est bouché, vous pouvez d'abord le rincer. Mais les filtres des humidificateurs restent des consommables, ils sont donc changés lorsqu'ils deviennent sales.
Moments de travail
Avec une mauvaise manipulation de l'appareil ou juste de temps en temps, certains éléments tombent en panne. La conception des humidificateurs d'air est assez simple, mais l'auto-réparation d'un purificateur d'air ne doit être effectuée que si vous avez des connaissances de base dans le domaine de l'électronique, des compétences en réparation et les outils nécessaires : un fer à souder, un multimètre, un tournevis.
Puanteur
Selon les règles de fonctionnement, l'eau doit être vidangée de l'appareil pendant les périodes d'inactivité, même si l'humidificateur n'est pas utilisé pendant une journée entière. Le non-respect de cette règle est à l'origine d'une odeur désagréable de moisi. Cela signifie qu'une colonie de bactéries s'est installée dans l'appareil, ce qui est agréable dans un environnement humide. De la moisissure sur les parois de l'appareil et de l'eau de ruissellement complètent le tableau.
Pour se débarrasser du problème, il est nécessaire de désinfecter l'appareil en rinçant les parties en contact avec l'eau et en remplaçant le liquide dans le réservoir. Un nettoyage en profondeur est effectué à l'aide de vinaigre de table. 3 cuillères à soupe. les acides doivent être versés dans l'appareil pendant 1 heure. Pour le nettoyage, du peroxyde d'hydrogène à 3 %, une solution d'acide citrique à 10 ou 20 % sont également utilisés. Le liquide est versé et le réservoir est soigneusement rincé à l'eau courante.
Parfois, il vaut la peine de remplacer ou de rincer le filtre avec de l'eau propre, car les bactéries s'y accumulent souvent. Certains modèles de filtres ne peuvent pas être nettoyés, ils peuvent uniquement être remplacés.
La membrane est nettoyée dans des appareils à ultrasons. Pour ce faire, débranchez l'appareil du secteur, puis retirez le panneau situé à l'arrière et l'attache, retirez le rouleau supérieur de la membrane et retirez celui du bas. La membrane elle-même est retirée, lavée à l'eau et séchée sur une serviette, puis installée dans l'humidificateur dans l'ordre inverse. N'exercez pas d'effet mécanique sur la membrane, par exemple, frottez-la avec une éponge métallique ou grattez avec un couteau, à cause de cela elle se décompose.
Après avoir allumé un nouvel humidificateur pour la première fois, il n'est pas rare que la pièce sente le plastique. Il est normal qu'au bout de 2-3 heures, il disparaisse et ne vous dérange plus par la suite.
Pas de vapeur

La vapeur est absente immédiatement après la mise en marche, ou au début, elle s'allume, mais s'arrête après quelques minutes. Le manque de vapeur indique des dommages à l'une des pièces responsables du chauffage de l'eau ou de la pulvérisation. Ceux-ci inclus:
- Générateur;
- membrane dans les appareils à ultrasons;
- ventilateur;
- l'unité électronique.
La nature de la panne ne peut être déterminée qu'en démontant l'appareil.
Pas d'air entrant
Ce dysfonctionnement se produit lorsque les passages d'air sont obstrués ou que le ventilateur tombe en panne. Si les lames tournent, mais lentement, cela vaut la peine de les nettoyer soigneusement. La saleté adhérente peut gêner la rotation. Le dysfonctionnement peut également être dû à l'absence de contact. Le ventilateur en panne doit être remplacé.
L'entrée d'air est nettoyée, le filtre est lavé ou remplacé. Si les mesures prises ne fonctionnent pas, il vaut la peine de faire réparer l'appareil.
Ne fonctionne pas du tout

Si l'humidificateur ne montre aucun « signe de vie », le problème peut provenir de la panne de courant de l'appareil. Il est nécessaire de vérifier l'intégrité de la fiche, de la prise, du fil, la présence d'électricité. Si aucun problème n'est détecté, démontez l'humidificateur, videz d'abord l'eau et séchez toutes les pièces. Il est nécessaire de vérifier le fonctionnement du fusible dans la prise d'alimentation, en le remplaçant en cas de panne. Les capteurs peuvent être endommagés.
Les humidificateurs d'air peuvent assainir l'atmosphère de votre maison, mais nécessitent un entretien quotidien. Si l'appareil est constamment utilisé et non nettoyé, il finira par faire plus de mal que de bien, et par la suite se décomposera assez rapidement. La réparation d'un humidificateur peut se faire à la main, mais certains problèmes devront être résolus dans un centre de service.









